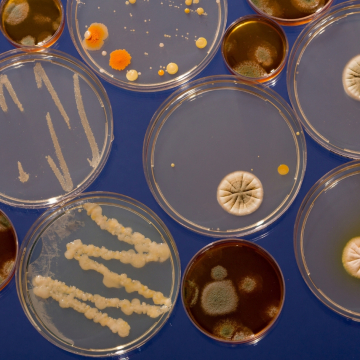
La importancia de los Microorganismos

Aprende a reciclar correctamente en casa con el código de colores de Perú. Guía completa para familias sobre materiales, limpieza y puntos de acopio.
Medio Ambiente
Información de interés general del calendario de Perú, blog con múltiple contenido del interés de todos.
Categorías
Fechas
305 artículos
Explorar categoríaTurismo
127 artículos
Explorar categoríaEducación
83 artículos
Explorar categoríaSalud
47 artículos
Explorar categoríaEstilo de vida
42 artículos
Explorar categoríaPerú
35 artículos
Explorar categoríaMedio Ambiente
29 artículos
Estás aquíTecnología
25 artículos
Explorar categoríaTrámites
18 artículos
Explorar categoríaEntretenimiento
15 artículos
Explorar categoríaArtículos en esta categoría
Día Mundial del Medio Ambiente en Perú y actividades para fomentar el cuidado del ecosistema este 5 de junio
Descubre cómo celebrar el Día Mundial del Medio Ambiente en Perú este 5 de junio con actividades educativas, consejos de cuidado y acciones sostenibles.
Importancia de las áreas naturales protegidas en el Perú y cómo visitarlas de manera responsable
Descubre por qué las áreas naturales protegidas son vitales para el Perú y aprende cómo visitarlas de forma responsable para conservar nuestra biodiversidad.
Cómo participar en el Simulacro Nacional Multiperiglo en Perú y qué elementos debe contener la mochila de emergencia
Guía completa para participar en el Simulacro Nacional Multiperiglo en Perú. Aprende qué llevar en tu mochila de emergencia y cómo proteger a tu familia.
Impacto del cambio climático en los glaciares peruanos y medidas para la conservación del agua
Análisis del impacto del cambio climático en los glaciares del Perú. Conoce las causas del deshielo y medidas para la conservación del agua en nuestro país.
Especies de la fauna peruana en peligro de extinción y cómo contribuir a su protección
Conoce las especies de la fauna peruana en peligro de extinción, los riesgos que enfrentan y acciones prácticas para contribuir a su conservación y protección.
Importancia de los humedales en el Perú y por qué debemos proteger estos ecosistemas vitales
Descubre por qué los humedales son vitales para el Perú. Conoce su importancia, los principales ecosistemas del país y cómo podemos protegerlos hoy.
Día de la Tierra en Perú 2026 acciones y compromisos para proteger nuestra biodiversidad
Descubre cómo celebrar el Día de la Tierra 2026 en Perú. Acciones prácticas, compromisos ambientales y guía para proteger nuestra biodiversidad nacional.
Lugares tranquilos del Perú para desconectarse y hacer turismo espiritual
Descubre los mejores lugares del Perú para desconectarte, meditar y hacer turismo espiritual en contacto con la naturaleza y la cultura andina.
¿Cómo elaborar ropa con materiales reciclados?
Cada vez más personas buscan alternativas que reduzcan el impacto ambiental de la industria textil, una de las más contaminantes a nivel global.
La importancia de las abejas para la vida
Las abejas son esenciales para la vida en la Tierra, ya que son las responsables de un servicio ecológico insustituible: la polinización.
La importancia de los Microorganismos
Estos organismos son ubicuos, es decir, pueden encontrarse en prácticamente todos los hábitats, desde el suelo y el agua hasta los ambientes más extremos.